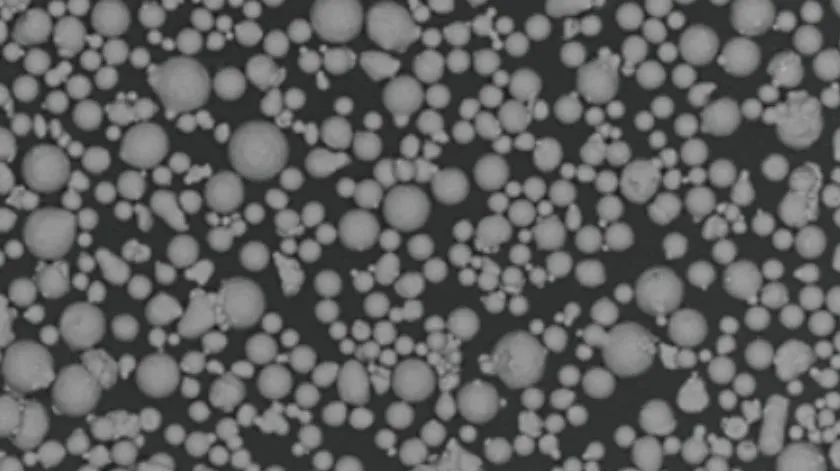

随着行业对轻质、高强材料需求增长,高温高强钛合金、高强铝合金、高温合金备受关注。近日,中航迈特充分发挥金属3D打印设备、材料及工艺一站式融合创新优势,取得一系列成果,并于TCT ASIA 2025展会发布多款新材料——高温钛合金粉、超高强韧钛合金粉、高强铝合金粉、抗开裂高温合金粉。

在钛合金领域,中航迈特通过探索材料成分微调、制粉、打印及热处理工艺,发布MT-Ti65、MT-Ti55531两款钛合金新材料,助力行业研究与应用。

高强铝合金方面,为解决高强铝合金激光选区熔化工艺(SLM)成形开裂等问题,中航迈特在MT-AlMgErZr基础上,优化调整Mg、Mn元素,开发出MT-AlMnErZr高强铝合金粉末。该粉末打印时烟尘、飞溅少,打印部件组织致密、无裂纹,致密度超99.9%,成形性能佳。热处理后,室温拉伸屈服强度≥510MPa,抗拉强度≥560MPa,延伸率>12%。

CM247LC是一种典型的镍基沉淀强化型高温合金,使用温度小于1050℃,合金中含有较高的铝元素,并含有钽和铪元素,具备高强度、抗蠕变和抗疲劳性能,广泛适用于涡轮转子叶片、导向叶片等高温精密零件制造。
针对该合金在增材制造中抗裂性能差的难点,中航迈特团队研究其裂纹萌生及生长机制,从成分与工艺入手,开发出MT-CM247LC高温合金粉末,有效抑制成形裂纹。该粉末已在TCT ASIA 2025展会发布,为行业提供了优质的难焊高温合金新材料 。

MT-Ti65 高温钛合金粉
材料特性
高温钛合金也称耐热钛合金,使用温度在400℃以上,被广泛应用于航空工业领域,特别是航空发动机高压压气机对600℃高温钛合金提出了迫切需求。
MT-Ti65是一种近 α 型高温钛合金,其长时使用温度为650℃,短时使用温度可达750℃,材料在高达 650℃环境下,仍具有高热强性、抗氧化性和热稳定性,高温综合力学性能卓越。

典型应用
发动机转子结构件
复合材料基体和高温短时结构件
发动机整体叶盘等航空领域
化学成分(wt.%)

物理性能

打印验证


金相组织

打印态
机械性能

制备技术
自主电极感应气雾化制粉技术

适配打印设备

MT-Ti55531 超高强韧钛合金粉末
材料特性
高强韧钛合金,根据强度可分为低强、中强、高强、超高强集中类型,超高强韧钛合金的核心指标为:抗拉强度≥1300 MPa。
MT-Ti55531是一种为高强度应用场景设计的3D打印用新型高强高韧β型合金,具有良好的淬透性和较宽的加工工艺范围,适合制造承力较大的零部件,可应用于航空航天领域,如结构件和起落架、机翼、发动机挂架之间连接装置等,也可应用于消费电子领域。

典型应用
适合制造承力较大的零部件
可应用于航空航天领域
如结构件、起落架、机翼等
也可应用于消费电子领域
物理性能

机械性能

制备技术
采用自主电极感应气雾化制粉技术

适配打印设备

MT-AlMnErZr高强铝合金粉末
材料特性
新一代高强铝合金粉末材料
专为大尺寸铝合金零件 SLM成形开发
典型应用
航空航天、轨道交通、汽车等
轻质高强部件制作
金相组织

室温力学性能

高温力学性能

制备技术
采用自主真空感应气雾化制粉技术

适配打印设备

MT-CM247LC高温合金粉末
材料特性
一种典型的镍基沉淀强化型高温合金
使用温度小于1050℃
具备高强度、抗蠕变和抗疲劳性能

典型应用
涡轮转子叶片
导向叶片等高温精密零件制造
化学成分(wt.%)

物理性能

金相组织

机械性能

制备技术
自主真空感应气雾化制粉技术

适配打印设备

当前,国内高温高强钛合金增材制造研究仍处初期阶段,亟需开发更高温度、更高强度的新型增材制造专用钛合金材料,中航迈特立足创新,在钛合金领域推出的MT-Ti65、MT-Ti55531响应市场要求,性能可靠。在铝合金领域推出MT-AlMgErZr及MT-AlMnErZr系列高强材料,以轻量化、高强度与优异综合性能填补行业空白,满足航空航天、轨道交通等领域需求。同时,其MT-K438(IN738)、IN939等难焊高温合金新材料凭借增材工艺适配性,显著拓展了航空航天、能源装备等高温场景应用。
未来,中航迈特将持续深研,助力行业前沿材料开发。
欢迎转发
欢迎加入硕博千人交流Q群:248112776
延伸阅读:
1.铂力特使用金属3D打印制造3D打印机!“工业母机”作用尽显!
3.五轴多激光同轴送丝3D打印平台,融速科技推动DED技术向高复杂度工业场景渗透

























 被折叠的 条评论
为什么被折叠?
被折叠的 条评论
为什么被折叠?








